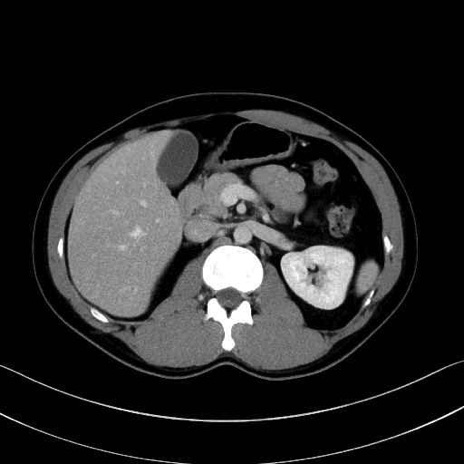
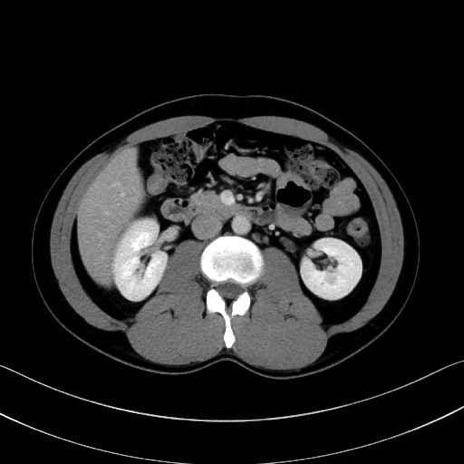
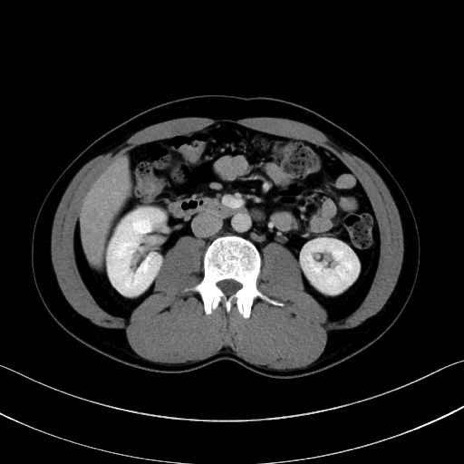

脾動脈(splenic artery)のCT画像における解剖
症例
【症例】20歳代 男性 スクリーニング
脾動脈の画像解剖
■起始:典型的には腹腔動脈幹(celiac trunk)から左胃動脈・総肝動脈とともに三分岐し、脾動脈は左後上方へ向かう。
■走行:膵上縁または膵実質背側を蛇行しながら左方へ進み、膵尾部近傍で脾門へ至る。蛇行の程度は個体差が大きい。
■終枝:脾門部で複数の終末枝に分かれ、上極・下極枝や脾門枝群を形成する。胃短動脈群や左胃大網動脈はしばしば脾動脈から分岐する。

【症例】20歳代 男性 スクリーニング
脾動脈の画像解剖
■起始:典型的には腹腔動脈幹(celiac trunk)から左胃動脈・総肝動脈とともに三分岐し、脾動脈は左後上方へ向かう。
■走行:膵上縁または膵実質背側を蛇行しながら左方へ進み、膵尾部近傍で脾門へ至る。蛇行の程度は個体差が大きい。
■終枝:脾門部で複数の終末枝に分かれ、上極・下極枝や脾門枝群を形成する。胃短動脈群や左胃大網動脈はしばしば脾動脈から分岐する。